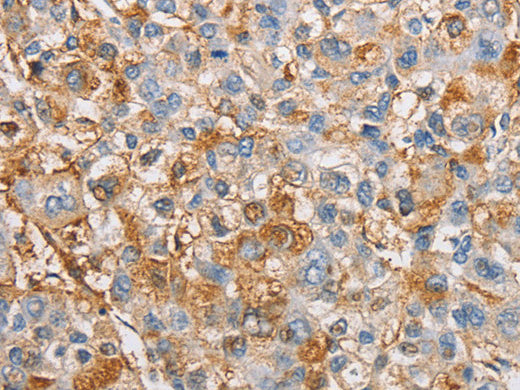
IKK Gamma Polyclonal Antibody Store at -20°C - MSE Supplies LLC

IKK Gamma Polyclonal Antibody Store at -20°C
Couldn't load pickup availability

Still have questions? Ask our experts!
IKK Gamma Polyclonal Antibody Store at -20°C
| SKU # | E-AB-10845 |
| Reactivity | Human, Mouse, Rat |
| Host | Rabbit |
| Applications | IHC |
Product Details
| Isotype | IgG |
| Host | Rabbit |
| Reactivity | Human, Mouse, Rat |
| Applications | IHC |
| Clonality | Polyclonal |
| Immunogen | Recombinant protein of human IKBKG |
| Abbre | IKBKG |
| Synonyms | IkB kinase subunit gamma, Inhibitor of nuclear factor kappa B kinase subunit gamma, AMCBX1, FIP 3, FIP-3, FIP3, Fip3p, I kappa B kinase gamma, I-kappa-B kinase subunit gamma, IkB k, IkB kinase associated protein 1, IkB kinase gamma subunit, IkB kinase subunit gamma |
| Swissprot | |
| Cellular Localization | Cytoplasm. Nucleus. Sumoylated NEMO accumulates in the nucleus in response to genotoxic stress. |
| Concentration | 0.3 mg/mL |
| Buffer | Phosphate buffered solution, pH 7.4, containing 0.05% stabilizer and 50% glycerol. |
| Purification Method | Affinity purification |
| Research Areas | Cancer, Cell Biology, Cardiovascular, Epigenetics and Nuclear Signaling, Immunology, Signal Transduction |
| Conjugation | Unconjugated |
| Storage | Store at -20°C Valid for 12 months. Avoid freeze / thaw cycles. |
| Shipping | The product is shipped with ice pack,upon receipt,store it immediately at the temperature recommended. |
Related Reagents
| Applications | Recommended Dilution |
| IHC | 1:50-1:200 |
Background
This gene encodes the regulatory subunit of the inhibitor of kappaB kinase (IKK) complex, which activates NF-kappaB resulting in activation of genes involved in inflammation, immunity, cell survival, and other pathways.Mutations in this gene result in incontinentia pigmenti, hypohidrotic ectodermal dysplasia, and several other types of immunodeficiencies.Multiple transcript variants encoding different isoforms have been found for this gene.A pseudogene highly similar to this locus is located in an adjacent region of the X chromosome.